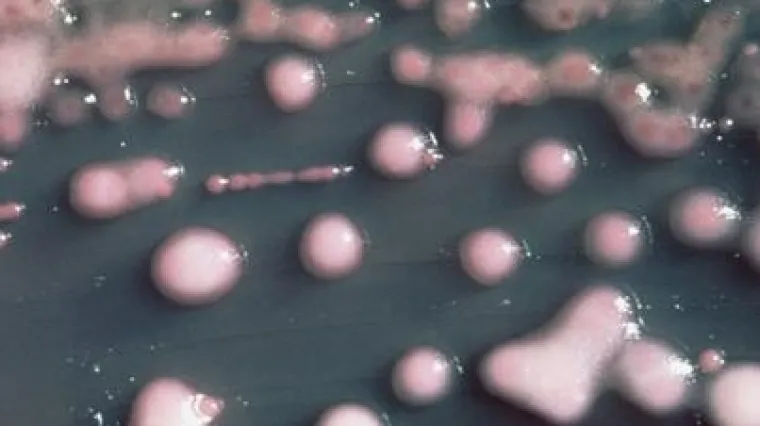
Prva žrtva superbakterije

Prva žrtva superbakterije
BRUXELLES - Superbakterija koja je otporna na gotovo sve antibiotike uzela je prvu žrtvu u Europi. U bolnici u Bruxellesu preminuo je Belgijanac koji se ovom superbakterijom zarazio u bolnici u Pakistanu. On je tamo doživio prometnu nesreću te su mu liječili ranu na nozi, a zatim ga iz bolnice vratili kući sa sepsom.
Superbakterija, nazvana New Delhi-Metallo-1 (NDM-1) stigla je u Europu iz južne Azije, a donijeli su je pacijenti koji su u taj dio svijeta putovali u sklopu medicinskog turizma. Do danas su NDM-1 pronašli kod 37 pacijenata u Velikoj Britaniji i kod njih trojice u Australiji.
Stručnjaci strahuju da bi se superbakterija mogla proširiti jer je otporan na gotovo sve poznate antibiotike, a istraživanja mogućeg lijeka još nisu ni započela.














